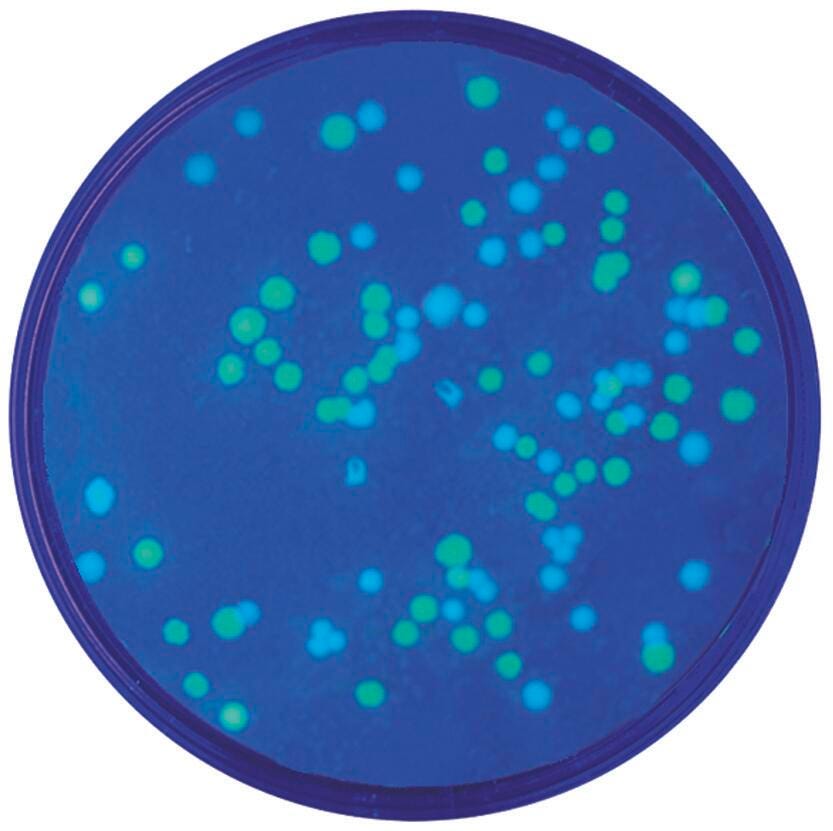

Close
Shop All:Edvotek
Edvotek Transformation of E. coli with Green & Blue Flourescent Protein Plasmids Kit
Item #:
1293212
$245.19
$122.60
package_2 Free Shipping Eligible.
Quickship Eligible.
In Stock - Typically Ships Within 2-3 Days
About This Item
Description
In this experiment, transformants acquire green (GFP) or blue (BFP) fluorescent protein genes contained in two different plasmids. The gfp gene, was originally isolated and cloned from the jellyfish Aequorea victoria, and was mutated to produce the blue protein. In this experiment, transformed cells are selected based on antibiotic resistance. The colonies which express gfp or bfp protein are visibly green and pale blue, and will fluoresce when exposed to long wave UV light commonly known as black light. Shipped ambient. Some components require -20 C storage. A downloadable PDF containing experiment components, requirements, background, procedures and MSDS is available.- a Downloadable Pdf Containing Experiment Components
- Requirements
- Background
- Procedures and MSDS
Shipping Type:
parcel
Free Shipping:
true
Attachments
Specifications
Grade Level:
High School-College
Maximum Age:
12 years
Allergens:
Contains No Allergens